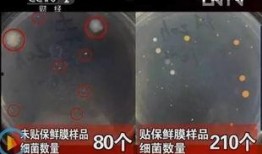

-
新闻爆料求助电话成都,守护城市脉搏,共建和谐家园
你知道吗?最近在成都,一个特别的电话号码引起了大家的关注。这个号码,就是成都市民的“新闻爆料求助电话”。今天,就让我带你一起来揭...
2025-09-01 22 -
抖音张美娟新闻爆料视频,揭秘背后真相
最近抖音上可是热闹非凡呢!有个叫张美娟的姑娘,她的视频爆料可是引起了广泛关注。咱们今天就一起来聊聊这个话题,看看这位张美娟究竟是...
2025-08-25 37 -
八月娱乐八卦爆料在线观看,独家爆料,精彩瞬间在线揭秘
你知道吗?八月的娱乐圈可是热闹非凡,各种八卦爆料层出不穷,让人眼花缭乱。今天,就让我带你一起揭开这些神秘的面纱,看看都有哪些精彩...
2025-08-24 34 -
娱乐圈爆料语音是什么,揭秘明星幕后真相
娱乐圈爆料语音是什么?亲爱的读者们,你是否曾在深夜里,被娱乐圈的八卦新闻所吸引?你是否好奇过,那些明星们私下里是如何谈论彼此的?...
2025-08-24 37 -
在恋爱娱乐吃瓜,揭秘娱乐圈甜蜜背后的故事
说到恋爱娱乐吃瓜,这可是个热门话题啊!你有没有发现,现在不管是电视剧、综艺节目,还是社交媒体上,恋爱和娱乐八卦总是能迅速抓住我们...
2025-08-23 37 -
新闻爆料要付钱吗知乎,知乎上的真相与争议
最近有个话题在知乎上炒得火热,那就是“新闻爆料要付钱吗?”这个问题可真是让人好奇不已。咱们就来聊聊这个话题,看看背后到底隐藏着怎...
2025-08-23 37 -
国服爱丁堡爆料了吗最新消息,最新消息揭秘即将到来的重大更新
最近国服爱丁堡可是成了游戏圈的热门话题呢!不少玩家都在翘首以盼,想知道关于它的最新消息。这不,小编我可是费了九牛二虎之力,搜集到...
2025-08-22 40 -
细菌实验室爆料视频大全,震撼爆料视频大全深度解析
你知道吗?最近网上有个超级火的视频系列,那就是“细菌实验室爆料视频大全”!是不是听起来就有点刺激?没错,就是那种让你心跳加速、好...
2025-08-22 42 -
新款跑鞋爆料视频教程下载,视频教程带你领略科技与舒适并存
最近有没有被新款跑鞋的爆料视频给吸引住了?那些炫酷的科技、时尚的设计,还有那轻盈的步伐,简直让人心动不已。别急,今天就来给你详细...
2025-08-22 40 -
关于青春的新闻爆料文案,揭秘校园里的青春故事与成长瞬间
亲爱的读者们,你是否还记得那些充满阳光、笑声和梦想的青春岁月?那些年,我们一起走过的路,一起度过的时光,如今都成了最珍贵的回忆。...
2025-08-21 36